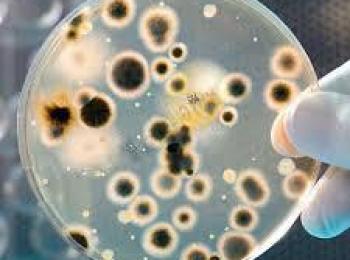
ابتكار طريقة بيئية لتفكيك النفط الخام باستخدام البكتيريا

نجح مجموعة من الباحثين العراقيين الشباب في ابتكار طريقة متقدمة وغير مكلفة لتفكيك النفط الخام باستخدام البكتريا.
وبين الباحثون الشباب واغلبهم من طلبة الدكتوراه ومنهم فراس الخطيب وامنة التماري ومناف جودة وعبد الحسين العضب والدكتورة كوثر هواز بأن ما يميز الطريقة المبتكرة عن سابقاتها للعلماء حول العالم انهم يستخدمون الخمائر والبكتيريا المفككة للمواد السامة حيث تترك هذه العملية مواد عرضية تؤثر في البيئة، إلا أن هذا الفريق العراقي نجح في العثور على البكتيريا المطلوبة التي تفكك النفط بفاعلية.
واثبتت الأبحاث المختبرية قدرة البكتيريا المذكورة على تفكيك المركبات الهيدروكربونية النفطية تماما تقريبا وخلال فترة قياسية تقدر بـ 3 - 4 أيام.
ونال الاكتشاف براءة اختراع عراقية كما نال براءة اختراع دولية سجلت في العاصمة الفرنسية باريس وصنفت عالميا.